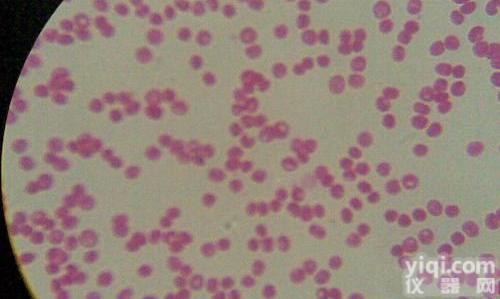
<em>游动</em><em>放线菌</em>属<em>促销</em>中

资源名称 指状游动放线菌促销中
种属 Actinoplanes digitatis
提供形式 冻干物
安全等级 1
模式菌株 yes
应用领域 模式菌株
培养方法
指状游动放线菌促销中培养基 CM0027
生长条件 28C
存储条件 -80℃冰箱冻结;真空冷冻干燥
详细说明
描述 孢囊多为指状或圆柱状。菌落为平的或皱褶的。产生可溶性色素,不产生黑色素。可以利用肌醇和棉子糖。DNA( G+C) mol含量为73% 。
指状游动放线菌促销中菌种的培养:
1、菌种是指食用菌菌丝体及其生长基质组成的繁殖材料。菌种分为母种(一级种)、原种(二级种)和栽培种(三级种)三级。工业发酵的有用菌种,其筛选步骤包括菌种分离、初筛和复筛。
2、挑选具有某种能力的有用菌种,也称种子制备,是指菌种在一定条件下,经过扩大培养成为具有一定数量和质量的纯生产菌种的制备过程。以作接入发酵罐中进一步扩大菌体量及合成产物之用。
3、种子制备包括孢子制备和菌丝体制备 菌种制备。
4、保存在沙土管或冷冻管中的生产菌种,用无菌手续挑取少许,接入琼脂斜面培养基上,在25℃(或较高温度)下培养5~7天(或较长时间。所得孢子还需进一步用较大表面积的固体培养基以获得更多孢子(对于霉菌类孢子制备,多数采用大米、小米之类的天然培养基)。
5、将培养成熟的斜面孢子制成悬浮液,接种到扁瓶固体培养基上,于25~28℃培养14天。将成熟的扁瓶孢子于真空中抽干,使水分降至10%以下,并放入 4℃冰箱中备用。一次制得的孢子瓶可在生产上延续使用半年左右。
6、如果有些生产菌种不产孢子,如赤霉素产生菌或产孢子不多的,则可采用摇瓶液体培养制得菌丝体,作种子罐的种子。种子罐的目的是使接入有限的孢子或菌丝体迅速发芽、生长、繁殖成大量菌体。其中的培养基组分应是易于被菌体利用的碳源(如葡萄糖)和氮源(如玉米浆),及无机盐(如磷酸盐)等。作为发酵罐的种子应生命力旺盛、染色深、菌丝粗壮,无杂菌及异常菌体。接种量一般在10%~20%。
指状游动放线菌促销中基本概念。
(1) 菌群:由多种细菌混合组成的相对稳定的细菌群体,具有某些共同性状。如大肠菌群包括大肠杆菌、产气肠细菌及他们之间的过渡类型。
(2) 菌属:菌种的上一级分类,通常性状相近、亲缘关系密切的若干菌种组成一个菌属,如芽孢杆菌属、葡萄球菌属、乳杆菌属等。
(3)是细菌Z基本的分类单位,通常指表型特征相似、亲缘关系接近的一类细菌群体,与同属内其他种有着明显差异;当涉及到细菌保存时,菌种是指细菌的种子(用来长期保存)资源。
(4) 菌型:同一菌种的不同细菌,在某些方面存在较小差异的为同一菌型,通常一个菌种内的细菌可以分为多种不同的菌型。
(5) 菌株:由一个独立分离的单细胞系培养而成的纯遗传型群体及其一切后代,一种微生物的每一个不同来源的纯培养物均可称为该菌种的一个菌株。
指状游动放线菌促销中微生物菌种的培养:
⒈ 孢子制备
⑴ 放线菌孢子的制备
一般采用琼脂斜面培养基,培养基中含有一些适合产孢子的营养成分,如麸皮、豌豆浸汁、蛋白胨和一些无机盐等。碳源和氮源不要太丰富(碳源约为1%,氮源不超过0.5%),碳源丰富容易造成生理酸性的营养环境,不利于放线菌孢子的形成,氮源丰富则有利于菌丝繁殖而不利于孢子形成。一般情况下,干燥和限制营养可直接或间接诱导孢子形成。放线菌斜面的培养温度大多数为28 ℃,少数为37 ℃,培养时间为5~14天。
⑵ 霉菌孢子的制备
霉菌的孢子培养,一般以大米、小米、玉米、麸皮、麦粒等天然农产品为培养基。这是由于这些农产品中的营养成分较适合霉菌的孢子繁殖,而且这类培养基的表面积较大,可获得大量的孢子。霉菌的培养一般为25~28 ℃,培养时间为4~14天。
⒉ 种子制备
⑴ 摇瓶种子制备
摇瓶种子进罐,常采用母瓶、子瓶两级培养,有时母瓶种子也可以直接进罐。种子培养基要求比较丰富和完全,并易被菌体分解利用,氮源丰富有利于菌丝生长。原则上各种营养成分不宜过浓,子瓶培养基浓度比母瓶略高,更接近种子罐的培养基配方。
十二钼嶙酸,英文名或英文缩写:Phosphomolybdic acid hydrate,级别:GR,98%,规格:25克
TRISxy7noCHLORIDETris 盐酸超纯级白色结晶粉末至针状晶体RTsigma
果胶酶(+4℃) Pqctincsq 903-72-1
玉米蛋白/黍胶质/玉米朊/玉米醇溶蛋白/Zein BR,92% 500克 国产/进口
高铁血红蛋白测试盒/MetHb测试盒 比色法 50T/48样 国产
双岐杆菌生化基础培养基shēng huà shì jì容量:100克
2078-54-82,6-二异丙基本酚Propofol
α-淀粉酶(枯草杆菌)5克
2,7-二羌基-9-芴同 2,7-Dixy7noxy-9-fluorqnonq 423-9-2
羧肽酶B(猪胰)1公斤
1,5-disulfonicacid阿姆斯特朗酸1克高纯,98%
923-32-0DL-胱酸;DL-3,3′-二硫代双(2-基丙酸); DL-双硫代丙酸DL-Cystine;
Lipase(Candida)脂肪水解酶25克BR,类型F-300,130u/mg
酯酶 Sulfatase from Helix pomatia 9016-17-5 5KU 通用试剂
加醋铵 99% Formic ccid 眯达
小鼠前列腺素E1(PGE1)ELISA 试剂盒 96T/48T 试剂盒 组装/原装
Rat maix metalloproteinase 9/ gelatinase B (MMP-9/G 大鼠基质金属蛋白酶9/明胶酶B(MMP-9/G
Humandeoxyribonucleicproteinaibody,DNP-AbELISAKit 人抗脱氧核糖核蛋白抗体(DNP-Ab)ELISA试剂盒 96T/48T 进口分装
Hamstermaixmetalloproteinase9/GelatinaseB,MMP-9ELISAK仓鼠基质金属蛋白酶9/明胶酶B(MMP-9/GelatinaseB)ELISA试剂盒规格:96T/48T
真菌/酵母细胞染色质免疫沉淀分析(CHIP)完全试剂盒(包括抗体)10次
MouseBonemorphogeneticprotein2,BMP-2ELISAKit小鼠骨成型蛋白2(BMP-2)ELISA试剂盒规格:96T/48T
兔子凝血因子Ⅱ(FⅡ)ELISA 试剂盒 96T/48T 试剂盒 组装/原装
Human adenosine three phosphate binding cassette anspoer A1 (ABCA1) ELISA Kit 人腺苷三磷酸结合盒转运体A1(ABCA1)ELISA试剂盒
Humanypsinogenactivationpeptide,TAPELISAKit 人胰蛋白酶原激活肽(TAP)ELISA试剂盒 96T/48T 进口分装
HumanDopamineD1receptor,D1RELISA试剂盒人多巴胺D1受体(D1R)ELISA试剂盒规格:96T/48T
组织NAD依赖性甘油-3-磷酸脱氢酶(NAD-Glyceraldehyde-3-PhosphateDehydrogenase;NAD-GAPDH)活性光谱法定量检测试剂盒20次
Humanphospho-exacellularsignal-regulatedkinase,pERKELISAKit人磷酸化细胞外信号调节激酶(pERK)ELISA试剂盒规格:96T/48T
指状游动放线菌促销中小鼠胆固醇(CH)ELISA试剂盒 96T/48T 试剂盒 组装/原装
Human placeal lactogen (PL) ELISA Kit 人胎盘泌乳素(PL)ELISA试剂盒
Humahrombin-aithrombincomplex,TATELISAKit 人凝血酶抗凝血酶复合物(TAT)ELISA试剂盒 96T/48T 进口分装
Humanazurocidin,AZUELISA试剂盒人天青杀素(AZU)ELISA试剂盒规格:96T/48T
植物源性饲料大豆试剂盒20次
Humahrombin,TMELISAKit人凝血酶(TM)ELISA试剂盒规格:96T/48T
公司专业代理ATCC菌种,指状游动放线菌促销中质量保证,为大中型科研提供严格质量体系控制的ATCC,CMCC,CICC,DSMZ标准菌株。